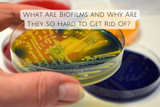
What Are Biofilms and Why Are They So Hard to Get Rid Of?

Almond Eyes Makeup: Tips & Tutorial
"Almond eyes" is a term used to describe a specific shape of eyes that resembles the shape of an almond nut. This eye shape is often characterized by eyes that are slightly upswept at the outer corners and taper to a narrower point near the inner corners. The term is commonly used in the context of describing physical features and can be found in literature, art, and discussions about beauty standards.
It's important to note that eye shapes can vary widely among individuals and cultures, and there is no single standard for what is considered attractive or desirable. The term "almond eyes" should be used with sensitivity and an understanding of the diversity of eye shapes and appearances.
Types of almond-shaped eyes:

Almond-shaped eyes are characterized by their balanced proportions and slightly pointed outer corners, giving them a classic and versatile appearance. While the almond shape is a general category, there can be variations within this eye shape that can influence makeup application and overall appearance. Here are some types of almond-shaped eyes and their characteristics:
1. Classic Almond Eyes
2. Large Almond Eyes
3. Small Almond Eyes
4. Close-Set Almond Eyes
5. Wide-Set Almond Eyes
6. Deep-Set Almond Eyes
7. Hooded Almond Eyes
8. upturned Almond Eyes
9. Downturned Almond Eyes
How To Do Makeup For Almond-Shaped Eyes

Makeup application can truly enhance the beauty of almond-shaped eyes. Almond-shaped eyes are known for their balanced proportions and slightly pointed outer corners, which allow for a variety of makeup techniques.
Here's a step-by-step guide on how to do makeup for almond-shaped eyes:
1. Prep the Eyelids:
Start by applying an eyeshadow primer to create a smooth base for your eyeshadow and to ensure it stays in place all day.
2. Apply Eyeshadow:
Transition Shade: Apply a neutral transition shade slightly above your natural crease to define the eye shape and provide a smooth transition between colors.
Lid Shade: Apply a slightly shimmery or matte eyeshadow on the eyelids. You can go for neutral tones or experiment with colors that complement your skin tone and eye color.
Outer V: Use a slightly darker eyeshadow shade to add depth to the outer corners of your eyes. This accentuates the almond shape and creates dimension.
3. Define the Crease:
Crease Shade: Apply a deeper eyeshadow shade to the crease of your eyelids. Focus on the outer half and blend well to create depth and dimension.
4. Eyeliner:
Upper Lid: Apply eyeliner along the upper lash line, starting thin at the inner corner and gradually thickening towards the outer corner. You can opt for a classic black or experiment with different colors.
Lower Lid: You can apply eyeliner to the lower lash line as well, starting from the outer corner and stopping about two-thirds of the way in. This can help enhance the shape of your eyes.
5. Mascara:
Apply mascara to both your upper and lower lashes to open up your eyes and make them appear larger and more defined.
6. Highlight:
Apply a light, shimmery eyeshadow orilluminator to the inner corners of your eyes. This adds a touch of brightness and makes your eyes appear more awake.
7. Brows:
Well-groomed eyebrows can frame your almond-shaped eyes beautifully. Fill in your eyebrows using a brow pencil or powder to define their shape and enhance the overall look.
8. Avoid Excessive Dark Eyeliner:
While eyeliner can define your eyes, avoid applying heavy eyeliner all around your eyes as it can make them appear smaller and less almond-shaped.
Each variation of almond-shaped eyes has its unique beauty and characteristics. Makeup techniques can be adapted to enhance and accentuate the specific features of your almond-shaped eyes, allowing you to create stunning looks that work harmoniously with your natural eye shape.
Tips for almond-shaped eye makeup

Certainly, here are some specific tips for doing makeup that complements eyes:
Emphasize the Outer Corners:
Almond-shaped eyes naturally have a beautiful taper towards the outer corners. Enhance this feature by applying slightly darker eyeshadow shades or eyeliner to the outer corners of your eyes. This will emphasize the almond shape and make your eyes appear more elongated.
Play with Eyeliner Styles:

Almond-shaped eyes are versatile when it comes to eyeliner styles. You can try a classic cat-eye by extending the eyeliner slightly past the outer corner or experiment with a soft smudged liner for a sultry look. Remember to keep the liner thinner towards the inner corners and gradually thicker towards the outer corners.
Highlight the Brow Bone:

Apply a matte or shimmery highlight shade on your brow bone to lift and define the area. This draws attention to your perfectly balanced eye shape.
Eyeshadow Placement:

When applying eyeshadow, focus the darker shades on the outer corners and crease, while keeping the center of the lid and the inner corners slightly lighter. This enhances the natural almond contour and brings attention to the center of your eyes.
Experiment with Color:

Almond-shaped eyes can achieve a wide range of eyeshadow colors. Earthy tones, warm shades, cool neutrals, and even vibrant colors can work well. Experiment with colors that complement your skin tone and eye color to make your eyes stand out.
Blend Well:

Blending is crucial for a seamless eye makeup look. Make sure to blend the eyeshadow shades together to avoid harsh lines and create a smooth transition between colors.
Opt for Soft Smoky Looks:

Almond-shaped eyes can look stunning with soft smoky eye makeup. Gradually blend darker shades from the outer corners into the crease, creating a subtle smoky effect that enhances the shape.
Inner Corner Highlight:

Applying a touch of shimmery eyeshadow or highlighter to the inner corners of your eyes can make them appear more open and awake.
Curl Those Lashes:

Curling your lashes can further emphasize the almond shape by opening up your eyes. Follow up with mascara to add volume and length.
Avoid Over-Exaggeration:

While it's great to play up your almond shape, avoid overdoing any makeup technique. Balance is key, and sometimes a simple, elegant look can be just as impactful.
Summary of almond eye makeup

Almond-shaped eyes are considered to be the most versatile eye shape and can pull off a variety of makeup looks. If you want to make your eyes look more elongated, focus on the inner corners by applying light eyeshadow or using a light-colored eyeliner on the inner rim of your eyes. You can also use false eyelashes to add volume and length to your lashes, which is a great way to make your eyes look more dramatic.
No matter what look you choose, make sure to have fun and experiment with different colors and techniques. Almond-shaped eyes are very versatile and can pull off a variety of looks.
Recent Posts
-
What Are Biofilms and Why Are They So Hard to Get Rid Of?
Biofilms are fascinating yet challenging structures that have significant implications for health, i
-
The Science Behind Boswellia Extract: How It Works in the Body
Boswellia serrata, also known as frankincense, is a resin obtained from the Boswellia tree that has
-
The Role of Un-Natured Protein in Enhancing Detoxification
While the human body is well-equipped with a detoxification system—primarily managed by the liver, k